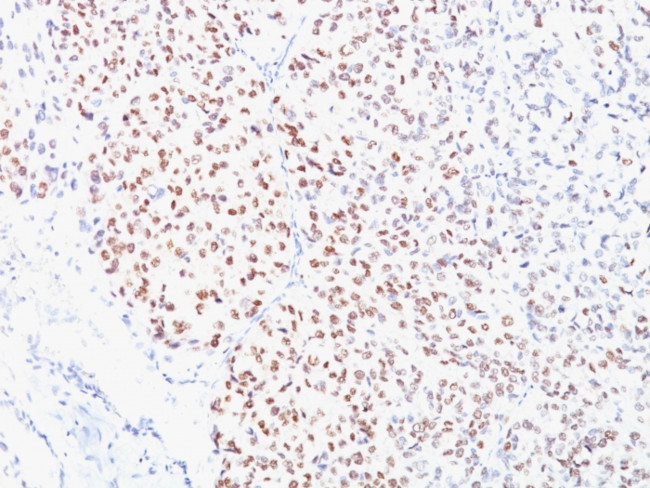
Microphthalmia Transcription Factor (MITF) Antibody in Immunohistochemistry (Paraffin) (IHC (P))

Search
NeoBiotechnologies
Microphthalmia Transcription Factor (MITF) Monoclonal Antibody (C5/D5)
{{$productOrderCtrl.translations['antibody.pdp.commerceCard.promotion.promotions']}}
{{$productOrderCtrl.translations['antibody.pdp.commerceCard.promotion.viewpromo']}}
{{$productOrderCtrl.translations['antibody.pdp.commerceCard.promotion.promocode']}}: {{promo.promoCode}} {{promo.promoTitle}} {{promo.promoDescription}}. {{$productOrderCtrl.translations['antibody.pdp.commerceCard.promotion.learnmore']}}
产品信息
4286-MSM1-P1ABX
种属反应
宿主/亚型
分类
类型
克隆号
抗原
偶联物
形式
浓度
规格
纯化类型
保存液
内含物
保存条件
运输条件
产品详细信息
Does not react with Mouse, Rat
靶标信息
Mi is a basic helix-loop-helix-leucine zipper (b-HLH-ZIP) transcription factor implicated in pigmentation, mast cells and bone development. The mutation of Mi causes Waardenburg Syndrome type II in humans. In mice, a profound loss of pigmented cells in the skin eye and inner ear results, as well as osteopetrosis and defects in natural killer and mast cells. There are two known isoforms of Mi differing by 66 amino acids at the NH2 terminus. Shorter forms are expressed in melanocytes and run as two bands at 52 kDa and 56 kDa, while the longer Mi form runs as a cluster of bands at 60-70 kDa in osteoclasts and in B16 melonoma cells (but not other melanoma cell lines), as well as mast cells and heart.
仅用于科研。不用于诊断过程。未经明确授权不得转售。
篇参考文献 (0)
生物信息学
蛋白别名: bHLHe32; Class E basic helix-loop-helix protein 32; melanogenesis associated transcription factor; microphtalmia-associated transcription factor; microphthalmia; Microphthalmia-associated transcription factor; unnamed protein product
基因别名: BHLHE32; CMM8; COMMAD; MI; MITF; MITF-A; WS2; WS2A
UniProt ID: (Human) O75030
Entrez Gene ID: (Human) 4286